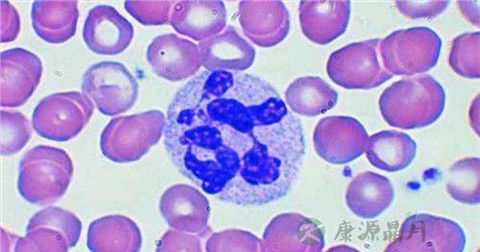

1、儿童白细胞偏高是怎么回事
儿童生病后,医学上常见的检查结果就是白细胞偏高,这个结果大部分是因为身体各方面出现感染造成的,比如说呼吸道感染就会造成白细胞的升高。
白细胞升高,说明身体有细菌感染,孩子的感染,大多是呼吸道或是消化道的感染居多,检查孩子的呼吸道,如鼻子是否通气,咽喉部是否疼痛,或咳嗽。是否有头痛,消化道方面,看宝宝是否有腹痛,厌食,便秘或腹泻,腹胀等,如果仔细观察,就不难发现问题的所在,医生会根据化验单和身体的体征做相应的处理,细菌感染可选用适当的抗菌素治疗,相应治疗后儿童一般都能很快康复。
2、白细胞偏高的治疗
首先是一般性治疗,急性期有高热者应卧床休息,鼓励多饮水、勤排尿、促使细菌及炎性渗出物迅速排出。

二是采用抗菌药物治疗,常选用抗革兰氏阴性杆菌药物,如复方新诺明2片,每日2次口服;呋喃呾啶0.1g,每日3次口服;新诺明1.0g,每日2次口服;头孢菌素Ⅵ0.25~0.5g,每日4次,氟哌酸0.2g,每日3次。
体温高,全身症状明显者,可用庆大霉素8万u,每日2次,肌注;氨苄青霉素50-100mg/kg,分4次口服或肌注。绿脓杆菌及变形杆菌感染者可用羧苄或磺苄青霉素。
3、白细胞增多如何预防
避免感冒,因为感冒可以导致白细胞异常,增加患病机会,如果发热同时伴有白细胞增高或中性粒细胞增高及“核左移”现象,是判断化脓性细菌感染的显着特点;预防感染,白细胞病理性增多是由于感染引起的,比如:急性感染、严重创伤、急性出血、急性中毒、白血病、恶性肿瘤等;慎重某些引起白细胞增多的药物,如某些抗生素和儿茶酚胺类药物等。
1、生命体征。应特别注意检查是否有提示感染或败血症的发热或体温过低症。发热也可提示有肿瘤、组织梗死或结缔组织病的可能(见发热)。低血压可伴随败血症同时发生。
2、神志改变,意识模糊、癫痫发作和局灶性异常深部肌腱反射可见于引起白细胞增高的许多情况,包括脑膜炎(感染性或肿瘤性)、败血症、白血病、淋巴瘤和实体肿瘤。
3、心动过速与急性应激反应一致。新出现的杂音,特别是有发热时,提示细菌性心内膜炎。寻找容量过多的证据,有时是由感染触发或与白血病或骨髓增殖性疾病。
4、检查可触及的淋巴结并注意其性质。软的淋巴结一般与感染有关。韧性和弥漫性肿大最常见于淋巴增殖性疾病如淋巴瘤。硬的、固定的、局限性的淋巴结提示恶性肿瘤的可能。
5、吸气时罗音提示有肺炎。呼吸音减轻和叩诊呈浊音提示有胸膜渗出或脓胸。胸膜摩擦音可伴有感染、恶性疾病、或其他情况如血栓性栓塞和SLE。
1、注意休息和睡眠,高热会增加小儿的能量消耗,此时增加儿童的睡眠时间,减少能量的消耗,将有利于机体与疾病的斗争。同时要为小儿安排一个良好的休息环境,室内保持安静,不要大声喧哗、过于吵闹;室温以20℃左右为宜,室内不要门窗紧闭,要保持空气新鲜,注意通风,要防止烟尘,切忌在室内抽烟。

2、注意饮食,发热会导致小儿体内水分散失较多,而且容易出现消化道功能紊乱,引起孩子的食欲下降。因此,此时不能强求孩子进食,而应减少食量,并增加饮水。 父母可以为孩子准备一些可口的、富有营养和容易消化的食物,以帮助孩子开胃。
3、做好降温工作,婴幼儿高热时易引起抽痉,因此当小儿体热太高时,父母应注意采取物理降温措施,一般可用冷毛巾、冰袋湿敷在额头或枕部,也可用35%-50%酒精擦头、上下肢、腋下和腹股沟等处,帮助散热;但注意,降温需要有个舒缓的过程,下降太快会让孩子不适应而出现其他症状。
豫公网安备 41110202000246号互联网药品信息服务资格证书:(豫)-经营性-2022-0039增值电信业务经营许可证:豫B2-20221313医疗器械经营备案编号:豫郑食药监械经营备20212188号



